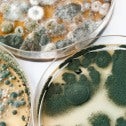

CUPE is pleased to offer the following materials to our members and locals. To place your order, complete the form below. Once you submit your order, you will receive a confirmation with an order number, and further instructions for payment if applicable.
Order CUPE pride items including apparel, head wear, promotional and custom items for your local from Universal Promotions at cupestore.com.
If you have any questions, please email orders@cupe.ca